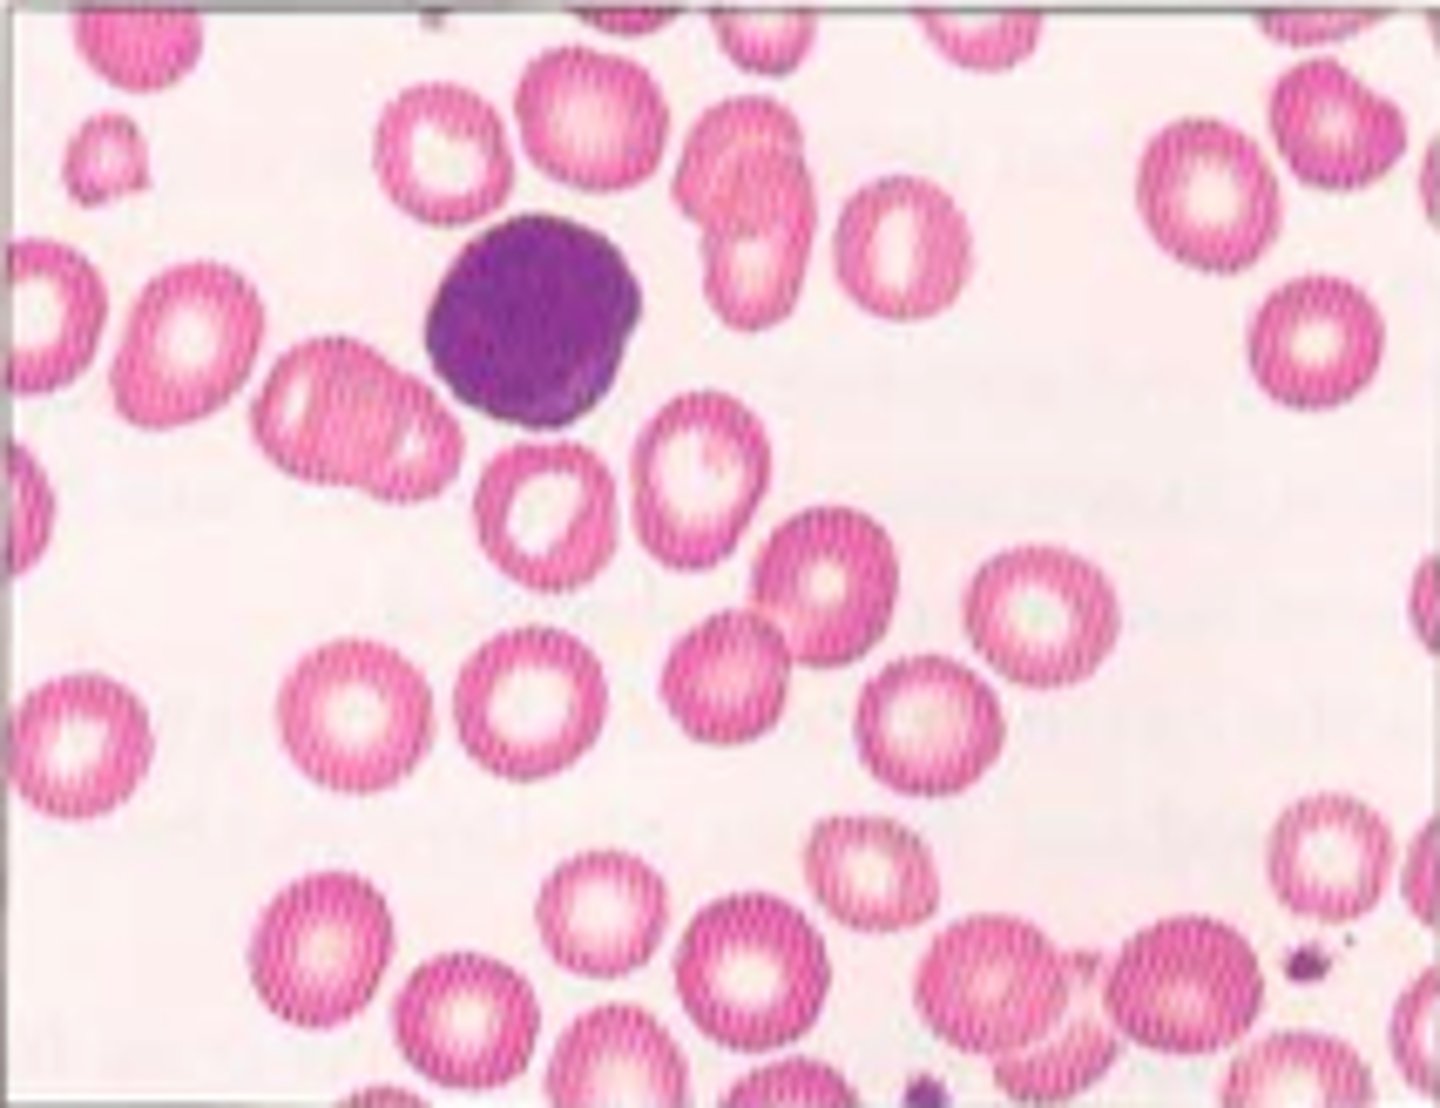
<p>condition in which the body does not have enough red blood cells due to lack of iron, which is a mineral essential for hemoglobin production</p>

1/142
Looks like no tags are added yet.
Name | Mastery | Learn | Test | Matching | Spaced | Call with Kai |
|---|
No analytics yet
Send a link to your students to track their progress
plasma
liquid portion of blood that holds blood cells in suspension. It makes up about 55% of total blood volume.
Fluid (90-92%):
Solutes (8-10%):
plasma fluid
Primarily Water. It acts as a solvent for transporting materials and helps maintain body temperature and blood pressure.
plasma solutes
Proteins: Albumin (osmotic pressure), Globulins (antibodies/transport), and Fibrinogen (clotting).
Electrolytes: Sodium, Potassium, and Calcium (vital for cell function).
Nutrients/Wastes: Glucose, amino acids, lipids, and metabolic waste like urea.
Gases: Dissolved Oxygen (O_2) and Carbon Dioxide (CO_2).

formed elements
erythrocytes, leukocytes, platelets
RBC, WBC, platelets
what makes up the buffy coat
leukocytes and platelets

Whole blood characteristics
1. Volume = about 4-6 liters (L)
2. pH = about 7.4- slightly alkaline
3. Color = oxygenated - bright red; deoxygenated - dark red
4. temp = 38 c

Hematocrit
percentage of blood volume occupied by red blood cells

erythrocytes
made from red bone marrow
almost all hemoglobin
donut shape
shape of erythrocytes
each subunit can bind to O2 molecules
every RBC can hold 1 billion O2 molecules
each subunit --> 250 mil

how does erythrocytes make energy
makes glucose through binding O2 molecules
Hemoglobin A1C tests glucose within 90 days
leukocytes
white blood cells (true cells)
types of leukocytes
granulocytes and agranulocytes
leukocytosis
increase in the number of white blood cells
average number of leukocytes
- 5,000-10,000 cmm of blood
- increases indicated bacterial infection
- decreases indicates viral infection
granulocytes
neutrophils, eosinophils, basophils
Neutrophils make up __________% of WBCs.
50-60%
function of neutrophils
phagocytize bacteria
neutrophil shape
multilobed nucleus

Eosinophils make up _____% of WBCs
5%
function of eosinophils
phagocyte for parasites
eosinophil shape
bilobed nucleus, red cytoplasmic granules

Basophils make up _____% of WBCs
1%
function of basophils
release histamine
basophil shape
bilobed nucleus, purplish-black cytoplasmic granules

Agranulocytes
lymphocytes and monocytes
lymphocytes make up ___?
25-30%
lymphocyte function
B and T cells (immune response)
lymphocyte shape
large nucleus

monocytes make up how much
10%
function of monocytes
phagocytosis; develop into macrophages in tissues
monocytes shape
Spherical, kidney-shaped, oval or lobed nuclei

Platelets function
blood clotting- occurs in plasma when blood vessels are ruptured/injured
leukemia
type of cancer involving WBC
impaired bone marrow function
lymphocytic leukemia
over production of faulty WBC
chronic; adults
acute; children

infectious mononucleosis
an infection caused by the Epstein-Barr virus (EBV) that is characterized by fever, a sore throat, and enlarged lymph nodes
increased numbers of lymphocytes and monocytes
increased number of mishappened WBC

how are platelets formed
by fragmentation of megakaryocytes
so big they cant get through bone marrow so they break up.

leukopenia
Abnormally low white blood cell count due to pharmacological threapies (cancer drugs)
iron deficient anemia
condition in which the body does not have enough red blood cells due to lack of iron, which is a mineral essential for hemoglobin production
lymphatic tissue
a specialized type of reticular connective tissue containing large numbers of lymphocytes
lymphatic organs
tonsils, thymus, spleen, lymph nodes, MALT, GALT
functions of lymph organs
1. filter
2. monitor/destroy
3. Seed bed- germinal centers
peyers patches
large collections of lymphoid tissue found in the submucosa of the small intestine

appendix
A small, fingerlike extension of the vertebrate cecum; contains a mass of white blood cells that contribute to immunity.

tonsils function
filters throat area, epithelial tissue over tonsils, tonsillar crypts (trap/destroy bacteria & particulate matter)
pharyngeal tonsil
also called adenoids; located in posterior wall of nasopharynx

palatine tonsils

lingual tonsils

lymph node
e

lymph node medulla

cortex of lymph node

germinal centers of lymph node
contain rapidly dividing B cells

spleen function
the largest lymphatic organ in the body; serves as a blood reservoir, disintegrates old red blood cells, and produces lymphocytes and plasmids
spleen
B

spleen microscope

white pulp of spleen
WBC

red pulp of spleen
RBC

vermiform appendix layers
1. mucosa
2. sub mucosa
3. muscularis externa
4. serosa
appendix mucoas type
simple columnar

appendix sub mucosa type
lymphatic tissue 2

appendix muscularis externa type
smooth muscle

appendix serosa type
fibrous

thymus gland
located in the mediastinal cavity anterior to and above the heart; secretes thymosin

red bone marrow function
produce red blood cells

lacteals function
Absorb digested fat and deliver chyle to the blood
small intestine

nasal cavity
hollow space behind the nose

paranasal sinuses
frontal, ethmoid, sphenoid, maxillary

frontal sinus
frontal bone

ethmoid sinus
Nasal Sinus located between the nose and the orbits.

sphenoid sinus
air-filled space located within the sphenoid bone; most posterior of the paranasal sinuses

maxillary sinus
sinus on either side of the nasal cavity below the eyes

respiratory muscosa
- mucosa lines the conducting portion of the respiratory system
- cilia resembles a shag carpet "sweeping" mucus across the epithelial surface
- debris or pathogens are trapped by the mucus and swept towards the pharynx
- swallowed and exposed to acids and enzymes of the stomach
PSCC

nasopharynx
part of the pharynx directly behind the nasal passages
PSCC
1

oropharynx
stratified squamous epithelium
2

laryngopharynx
the third division of the pharynx, is shared by both the respiratory and digestive systems
3

auditory canals
Outside of the ear that you see, captures sound as sound waves go through

thyroid cartilage
The wing-shaped plate of cartilage that sits anterior to the larynx and forms the Adam's apple.

hyoid bone
U-shaped bone at the base of the tongue that supports the tongue and its muscles.

epiglottis
a flap of cartilage at the root of the tongue, which is depressed during swallowing to cover the opening of the windpipe.

vocal folds
Mucosal folds that function in voice production (speech); also called the true vocal cords.

vestibular folds
(false vocal cords)
Superior to vocal folds
No part in sound production
Help to close glottis during swallowing

glottis
Opening between vocal cords

cricoid cartilage
the ring-shaped structure that forms the lower portion of the larynx

laryngeal prominence
Adam's apple

superior nasal conchae

middle nasal conchae

inferior nasal conchae

function of nasal conchae
lined with mucosa
humidifies, warms, filters air
larynx
voice box; passageway for air moving from pharynx to trachea; contains vocal cords

soft palate
a muscular flap that closes off the nasopharynx during swallowing or speaking

uvala

trachea
Allows air to pass to and from lungs
conducts air
cartlingeous c shaped rings

bronchial tree
branched airways that lead from the trachea to the microscopic air sacs called alveoli

terminal bronchioles
smaller than 0.5 millimeter and these mark the end of the conducting zone

aveolar duct
Smallest of Bronchi
Flat
Made of simple squamous epithelium.
Walls entirely made of alveoli.
Lead to terminal clusters called alveolar sacs.

alevoli
tiny air sacs at the end of each bronchiole. surrounded by a capillary network

smokers lung
Inflammed, narrowed airways, destroyed alveolar walls.
High airways resistance, and high alveolar compliance

pleural membranes
double-layered serous membrane surrounding each lung

plural cavity
part of the thoracic cavity that holds the lungs

rhinitis
inflammation of the nasal mucosa

sinusitis
inflammation of the sinuses
